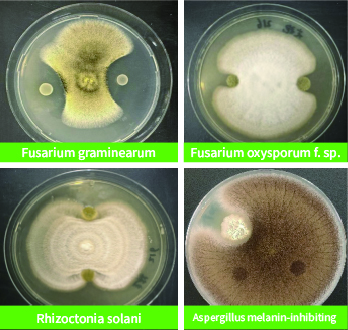

Hua Yi Kun®
Microbial Fertilizer
Main Technical Indicators: Viable Count > 5.0 Billion CFU/mL
Effective Strains: Bacillus subtilis, Bacillus amyloliquefaciens, Paenibacillus mucilaginosus
Form: Liquid
Specifications: 1kg/bottle, 20kg/pot
Effective Strains: Bacillus subtilis, Bacillus amyloliquefaciens, Paenibacillus mucilaginosus
Form: Liquid
Specifications: 1kg/bottle, 20kg/pot
Product efficacy
Rich in hundreds of antimicrobial peptides, with broad-spectrum and powerful bacteriostatic effects, and multiple stress resistance and disease prevention capabilities.
High density and high activity, rapid and quick onset, long-lasting and stable efficacy.
Activate the soil microecology, regulate the microbial community environment, and enjoy green health without worries.
Applicable crops, application methods and dosages
| Crop | Application period | Dosage | Application method |
|
Field crops |
Seedling stage, maturity stage |
Apply 15kg-30kg per hectare, diluted 100-200 times |
Flood application, drip irrigation, spray application |
| Vegetable crops | Rapid growth period | Apply 15kg-75kg per hectare, diluted 100-200 times |
Flood application, drip irrigation, spray application |
1、This product should be stored in a well-ventilated, cool, and dry place. It is recommended to use it up on the same day after dilution.
2、This product should be sprayed on the surface of plant leaves.
3、This product must not be mixed with fungicide products at the same time.
Scientific Experiment
Screen biocontrol strains that can inhibit various plant diseases
Demonstration Application

Cotton plants treated with bacterial agents have more developed root systems, enhanced disease resistance, increased number of bolls, and at 7.5% increase in yield.

